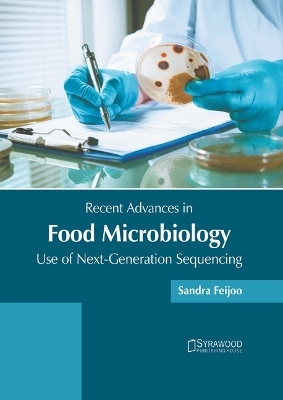
Recent Advances in Food Microbiology: Use of Next-Generation Sequencing -

Recent Advances in Food Microbiology: Use of Next-Generation Sequencing
Seiten
2025
Syrawood Publishing House (Verlag)
978-1-64740-530-4 (ISBN)
Syrawood Publishing House (Verlag)
978-1-64740-530-4 (ISBN)
- Titel nicht im Sortiment
- Artikel merken
| Erscheinungsdatum | 02.09.2025 |
|---|---|
| Sprache | englisch |
| Themenwelt | Technik ► Lebensmitteltechnologie |
| ISBN-10 | 1-64740-530-0 / 1647405300 |
| ISBN-13 | 978-1-64740-530-4 / 9781647405304 |
| Zustand | Neuware |
| Informationen gemäß Produktsicherheitsverordnung (GPSR) | |
| Haben Sie eine Frage zum Produkt? |
Mehr entdecken
aus dem Bereich
aus dem Bereich
Technologie, Chemie, Mikrobiologie, Analytik, Bedeutung, Recht
Buch | Hardcover (2023)
Verlag Eugen Ulmer
CHF 169,00
A Laboratory Manual
Buch | Softcover (2022)
John Wiley & Sons Inc (Verlag)
CHF 103,00
Hygieneanforderungen und Managementsysteme
Buch | Softcover (2025)
DIN Media (Verlag)
CHF 307,55


